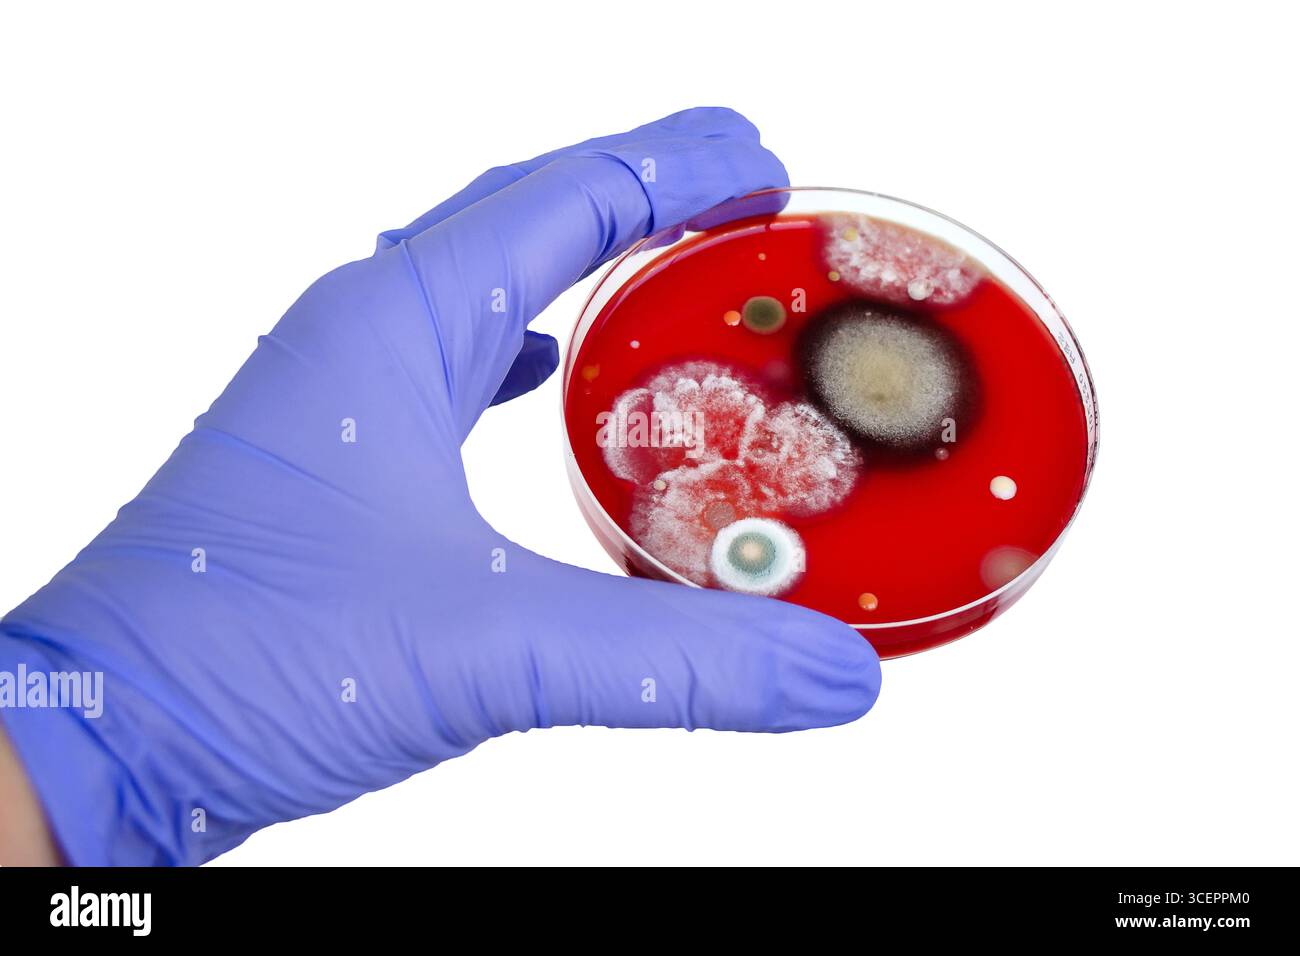
Colonies de champignons de moisissure cultivées à partir de l'air intérieur sur gélose Blood Sheep, photographie montrant la diversité microbienne et la contamination de l'air. Banque D'Images

Colonies de champignons de moisissure cultivées à partir de l'air intérieur sur gélose Blood Sheep, photographie montrant la diversité microbienne et la contamination de l'air.
RFID:ID de l’image:3CEPPM0
Détails de l'image
Contributeur:
Dr_MicrobeID de l’image:
3CEPPM0Taille du fichier:
71,6 MB (1,3 MB Téléchargement compressé)Autorisations:
Modèle - non | Propriété - nonUne autorisation est-elle nécessaire?Dimensions:
6128 x 4085 px | 51,9 x 34,6 cm | 20,4 x 13,6 inches | 300dpiDate de la prise de vue:
14 mars 2025